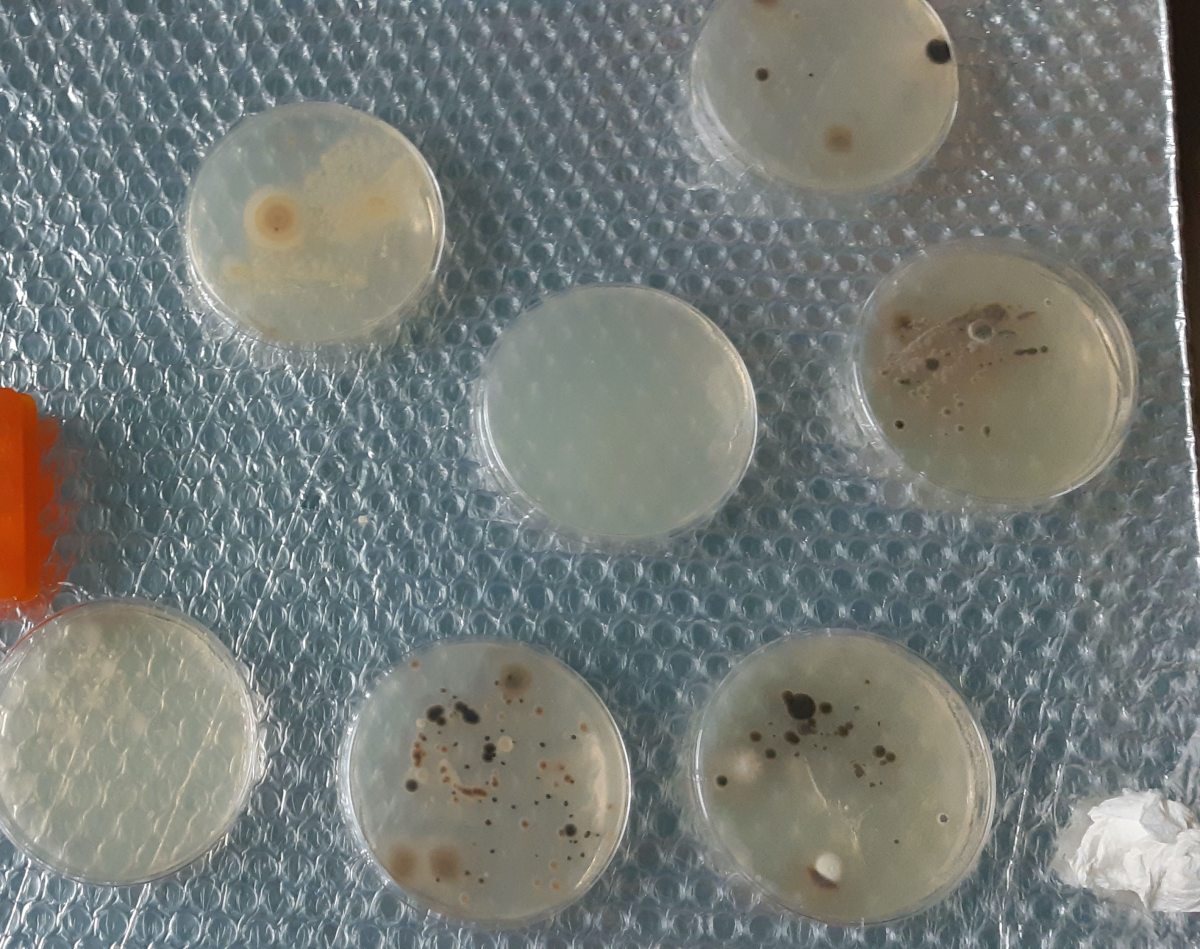
CRISPR Results! 크리스퍼 결과! (24&nbsp;HRS)

CRISPR Cas9 DAY 1! 크리스퍼 실험 1일차!
A few weeks ago, I bought a DIY Bacterial Gene Engineering CRISPR Kit from The ODIN right before my summer break began. I distracted myself from the excitement about this kit by studying extremely hard for my last finals exams of 9th Grade.…
Read MoreCRISPR Cas9 DAY 2! 크리스퍼 실험 2일차!
On Friday(June 19th, 2020) , I started building my Petri Dishes. 금요일에 제가 페트리 접시에 박테리아가 자랄 아가(한천) 젤을 담았어요. Another problem occurs here! I was first supposed to build my LB Agar Petri Plates, but I accidentally mistakened LB Strep/Kan/Arabinose Agar as…
Read MoreCRISPR DAY 3! 크리스퍼 실험 3일차!
Time to add the bacteria! I mistakened the word “fridge” as the freezer instead of the refrigerator because it said the bacteria should be stored in an environment of 4°C, and I thought the refrigerator wasn’t cold enough. 이제 박테리아를 키울 시간이에요! 영어로…
Read MoreCRISPR DAY 4! 크리스퍼 실험 4일차!
Making the actual CRISPR fluid!! 이제 드디어 박테리아의 유전자를 편집할 시간!! To make the CRISPR solution, it is required to make the bacterial transformation mix, which will serve as a base. To make the bacterial transformation mix, a small portion of the bacteria…
Read MoreCRISPR Results! 크리스퍼 결과! (24 HRS)
The results I had expected after 24 hours did not seem to show very evidently. 원래 기대했던 결과가 생각보다 많이 안 나타나서(?) 좀 실망했어요. Interestingly, there were black circles on both the LB Agar and LB Strep/Kan/Arabinose Agar plates. I think they are…
Read MoreCRISPR Results! 크리스퍼 결과! (48 HRS)
I was able to see much more substantial growth after another 24 hours since my first check-in with the two Agar plates. The bacteria in the LB Agar plates grew even more than the results the day before, and I was glad that…
Read MoreCRISPR Experiment Conclusion!
I remember when I was extremely anxious and frightened to even lay a hand on a bacterial tube because I had never tried a serious experiment like this before. Before starting this experiment, I was not fully looking forward for this experiment because…
Read MoreGet new content delivered directly to your inbox.